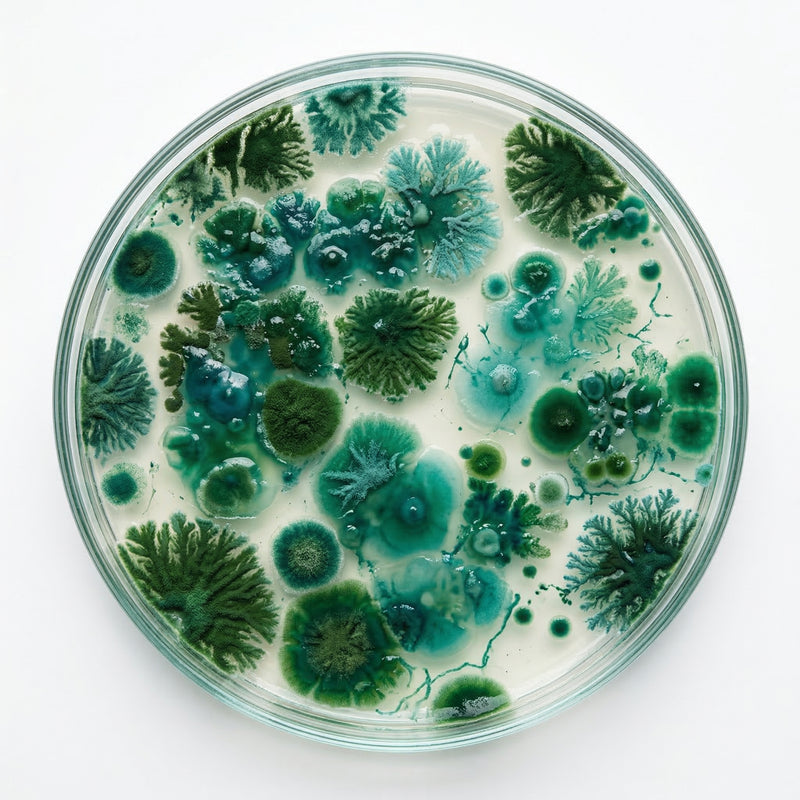

Your daily defense
against chemicals
you never chose.
8 clinical-dose actives formulated to support your body's natural elimination of environmental chemicals, PFAS, and microplastics.








Daily Defense Powder
Detoxify from the hidden chemicals linked to fatigue, weight gain, brain fog & hormonal disruption in one spoon
- Weight Loss
- Energy & Focus
- Hormone Balance
- PFAS Detox
- Toxin Defense
- Immune Support
Order by to claim discount
SELECT YOUR PACK: 30 Doses
CHOOSE YOUR PLAN:
Try it Risk-free for 30 days. If you're not totally in love with the product, we will refund you 100%.
Due to extreme demand and limited raw materials, this product sold out 12 times. We encourage you to take advantage of the limited sale and buy before sold out.
Full supplement facts panel — 8 clinical-dose actives including activated charcoal, chlorella, modified citrus pectin, NAC, calcium-D-glucarate, milk thistle extract, alpha lipoic acid, and selenium.
Daily Defense Powder is a precision-formulated blend of 8 clinical-dose actives designed to support your body's natural elimination of environmental chemicals including PFAS, microplastics, and heavy metals. Each ingredient is dosed at the levels used in published research — no proprietary blends, no fillers.
Mix 1 scoop with a glass of water. Take every morning with breakfast. For best results, use consistently for 30+ days.

Dr. Kenji Tanaka, MD
Most people are unknowingly exposed to hundreds of daily chemicals. Everblends intercepts these toxins in the gut before they enter the bloodstream, and supports your body's natural detox pathways to eliminate existing buildup
*These statements have not been evaluated by the Food and Drug Administration. This product is not intended to diagnose, treat, cure, or prevent any disease.
THE PROBLEM
You're intoxicated from inside
And these toxins won't break down.
of Americans carry PFAS in their blood.
Linked to cancer & liver damage.
of plastic found in the average human brain. That's a full spoon.
Inflammation & neurological decline.
the time mercury can stay lodged in your brain.
Alzheimer's & cognitive decline.
Real Stories, Real Results
See what our customers are saying about Everblends⁹⁸













"My husband asked what I'm doing differently"
I'm 57 and I've accepted that weight loss was behind me. Tried this because my daughter sent me an article about forever chemicals and it scared me. 8 weeks in down a full pant size, my skin looks better than it has in years, and I have energy to actually walk the dog again
"Something actually shifted"
I bought this for the detox angle, wasn't expecting much else. But around day 10 I realized I wasn't hitting that 2pm wall anymore. I'm a nurse and I work 12-hour shifts. notice when my brain works better. The weight stuff is starting too (down 8 lbs at week 4) but honestly the mental clarity alone is worth it
"The brain fog thing is real"
For the first time in years, I actually saw something leave my body. I was shocked. I've tried everything for my gut and skin issues, and this is the only thing that's made a noticeable difference. My skin is clearer and I feel so much more focused.
"Slow start but I'm a believer now"
Giving 4 stars because weeks 1-2 were underwhelming and I almost returned it. My sister talked me into sticking with it. Week 3 something clicked — sleeping deeper, less moody before my period, and the puffiness in my face went down. Just ordered my second bag. Taste is fine, not amazing, but I mix it with OJ and it's easy
THE SCIENCE
8 clinical-dose actives. One mechanism.
Each ingredient targets a specific step in the Intercept | Eliminate | Defend pathway.

B-GLUCAN
Why it's here: Binds to PFAS in your gut before they reach your bloodstream.

BLUE SPIRULINA
Why it's here: Natural antioxidant pigment

MCP
Why it's here: Intercepts heavy metals and helps your body flush them out.

PSYLLIUM HUSK
Why it's here: Creates a fiber matrix that traps toxins and carries them out.

NAC
Why it's here: Fuels your liver's detox pathways — your body's main filter.

FUNGAL CHITOSAN
Why it's here: Binds heavy metals in your gut before absorption.

GLYCINE
Why it's here: Supports cellular repair and your body's natural detox cycles.

SILYMARIN
Why it's here: Protects liver cells from the damage toxins leave behind.

CHLORELLA
Why it's here: Binds mercury and supports whole-body elimination.


What to expect.

BENEFITS
What happens when your body stops fighting toxins

ENERGY
Less toxic load and less inflammation. Your body stops wasting energy.

WEIGHT
Your body stores toxins in fat to protect your organs. Everblends flush them out.

MIND
The fog lifts. You think faster, focus longer, and feel like yourself again
HORMONES
Remove the chemical disruptors and your body recalibrates on its own
THIRD-PARTY TESTED
CLINICAL DOSES
RESEARCH-BACKED
NO FILLERS
EVERBLENDS VS OTHERS
How we measure up

HOW TO USE
Daily protocol
1 scoop. 1 glass of water. Every morning with breakfast.
Start your defense
Join thousands who've made Daily Defense part of their morning routine.
Add to CartWhen is the best time to take it?
Take it every morning with breakfast and a full glass of water. Consistency is key — the ingredients work best as part of your daily routine.
Is it compatible with other supplements?
Yes. Daily Defense Powder is designed to complement your existing routine. If you're taking prescription medication, consult your healthcare provider first.
How long before I feel results?
Most users report noticeable changes in energy and clarity within 2-3 weeks. The full detoxification support benefits build over 30-60 days of consistent use.
*These statements have not been evaluated by the Food and Drug Administration. This product is not intended to diagnose, treat, cure, or prevent any disease.










